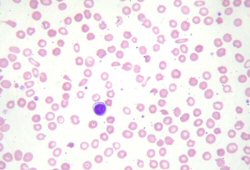
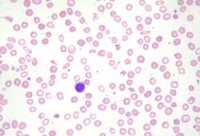

Images and videos
Images

Iron deficiency anaemia
Koilonychia
Reproduced with permission from Bickle Ian. Clinical exam skills: Hand signs BMJ 2004;329:0411402
See this image in context in the following section/s:
Iron deficiency anaemia
Peripheral blood smear demonstrating some changes often seen with iron deficiency anaemia. Note that many of the red cells are microcytic (compare size of red cell with the lymphocyte nucleus) and hypochromic (wide central pallor). There are some pencil forms
From personal collection of Dr Rebecca Fischer Connor; used with permission
See this image in context in the following section/s:
Use of this content is subject to our disclaimer